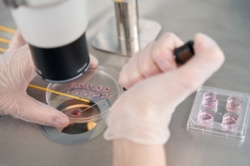
Dzieci na zamówienie? Rodzice płacą fortunę za "inteligentne" embriony

#ankieta #nauka #inteligencja #badanianaukowe #naukowcy #naukowiec
#inteligencja
Zaloguj się aby komentować

Wskaźnik inteligencji poszczególnych krajów
W Internecie dostępny jest bezpłatny test IQ, porównujący ten wskaźnik pomiędzy różnymi państwami. Jeśli lubicie testy, w których trzeba domyślić się jaki będzie szósty obrazek, to możecie się tutaj wykazać. Zdobyłem 108 punktów, ("Znajdujesz się w górnych 30% na całym świecie (uzyskałeś wynik...
Dzieci na zamówienie? Rodzice płacą fortunę za "inteligentne" embriony
W Dolinie Krzemowej rodzi się nowy trend, który jeszcze niedawno wydawał się domeną literatury science fiction. Coraz więcej zamożnych rodziców decyduje się na inwestowanie ogromnych sum – sięgających nawet 50 tysięcy dolarów – w zaawansowane badania genetyczne embrionów. Celem jest nie tylko...
Zaloguj się aby komentować
"Nasza młodzież obecnie kocha luksus, ma złe maniery, gardzi autorytetami i nie okazuje szacunku starszym. Dzieci sprzeciwiają się rodzicom, plotkują w towarzystwie, pożerają jedzenie i tyranizują swoich nauczycieli" - Sokrates, V w. p.n.e.
„Ech, starzy po prostu tego nie rozumieją” - Julka, XXI w. n.e.
Odwieczny konflikt pokoleń, narzekanie na głupotę młodzieży i stękanie na niewiedzę starych.. Czy coś w tym jest?
Ciężko określić czy chociaż zdefiniować 'mądrość', więc z braku lepszych pomysłów posłużę się badaniami IQ, a więc 'inteligencją' poszczególnych pokoleń.
Przez większość XX i początek XXI wieku obserwowano systematyczny wzrost średniego IQ w społeczeństwach rozwiniętych, co nazwano efektem Flynna. Średni wzrost wynosił ok. 3 punkty IQ na dekadę.
Ostatnie badania w krajach wysoko rozwiniętych pokazują, że efekt ten ulega odwróceniu. Badania w Norwegii, Danii, Wielkiej Brytanii, Francji, Australii i USA pokazują, że średnie IQ spada obecnie o 2–4 punkty na pokolenie w niektórych krajach.
Np. na Uniwersytecie Northwestern, w latach 2006-2018 zaobserwowano spadki w trzech z czterech badanych 'obszarów' inteligencji.
W Norwegii analiza ponad 730 tys. wyników testów poborowych wykazała, że mężczyźni urodzeni w 1991 roku mieli wyniki o 5 punktów niższe niż ci urodzeni w 1975 roku, i o 3 punkty niższe niż urodzeni w 1962 roku
Czy to oznacza, że pokolenie '70-'90 osiągnęło peak inteligencji i może stosować oba cytaty z początku jako prawdziwe? ( ͡° ͜ʖ ͡°)
Co o tym myślicie? Kto jest głupszy?
#inteligencja #socjologia #ciekawostki #zuchpostuje #rozkimnyzucha #statystyki #spoleczenstwo


Które pokolenie jest mądrzejsze?
Zaloguj się aby komentować
To wyjaśnia czemu ludzie w internecie są aż tak tępi :v super, że mamy powszechną edukację.
#zdrowie #inteligencja #edukacja

@maximilianan a będzie tylko gorzej, bo już sam Microsoft zrobił wstępne papiery nt stopnia obniżenia krytycznego myślenia u osób korzystających z llmów. Jak tylko AI wjedzie w mainstream, to bez reformy edukacji staniemy w sytuacji, kiedy będziemy mieli szamanów umiejących w technologię i niepiśmiennych chłopów.
Zaloguj się aby komentować

13-latka z tytułem inżyniera. Ma IQ wyższe od Einsteina i Hawkinga
Adhara Perez Sanchez otrzymała dwa dyplomy akademickie i dalej rozwija naukę, podejmując studia magisterskie z matematyki w Technological University of Mexico. 13-latka wyróżnia się IQ wyższym niż Einstein czy Hawking.
Gdy Adhara Pérez Sánchez miała trzy lata, wykryto u niej zespół Aspergera....

Zanieczyszczenie ołowiem w starożytnym Rzymie obniżyło IQ Europejczyków
Ślady zachowane z arktycznym lodzie wskazują, że mieszkańcy całego Imperium Rzymskiego byli narażeni na wysokie stężenia ołowiu w powietrzu. W nowych badaniach naukowcy ustalili, że zanieczyszczenia te prawdopodobnie doprowadziły do ogólnego spadku IQ i odporności na choroby.
Ekspozycja na ołów...
Dzisiaj @maximilianan wrzucił post o tym jak ludzie o niskimi ilorazie inteligencji postrzegają świat. Zachęciło mnie to do sprawdzenia siebie, więc odpaliłem jakiś losowy test w internecie.
Chwilę mi zajęło jego rozwiązanie no i wynik nie jest podawany na stronie a przysyłają go bardzo szybko mailem. Podałem oczywiście mail służący do kumulowania spamu i nie zachęcam was do używania swojej głównej skrzynki.
Test jest tu: https://szaloneliczby.pl/test-iq/
Pamiętajcie, że to jest zabawa a wyniku nie traktujcie bardzo poważnie.
No i zachęcam do przeczytania posta @maximilianan , którego sam ładnie posumował:
ludzie o niskiej inteligencji zdanie "jeśli p to q" rozumieją "p oraz q" - nie potrafią zrozumieć hipotetycznych sytuacji z jakimś warunkiem. Dla nich pytanie "jak byś się czuł gdybyś wczoraj nie zjadł śniadania" jest bez sensu bo przecież zjedli wczoraj śniadanie.
Dla nich zadanie "napisz historyjkę gdzie rozmawiają dwie osoby, a jedna z nich opowiada o dwóch innych osobach" jest zbyt trudne i się gubią.
Ludzie z IQ poniżej 80 mają tendencję do nie rozumienia abstraktów typu "jak by się ktoś czuł gdybyś zabił jego bliskiego".
#inteligencja #iqtest #iq

@CzosnkowySmok - jestem zbyt niecierpliwy na takie testy - ale przez lata robiłem sobie różne - i zauważyłem, że nauczyłem się je lepiej rozwiązywać i że one są robione od jakiejś takiej sztampy - co pozwala mi spędzać mniej czasu nad każdym z nich by rozpoznać wzorce.
Śmieszne jest to, że jak z takimi testami zaczynałem to byłem lekko powyżej średniej - a teraz jestem dużo powyżej średniej - a jaki z tego morał? Nie wiem - możne nauczyłem się rozwiązywać testy na inteligencję (a wcale nie jestem taki inteligenty
Pamiętam jak byłem młodszy (więc i głupszy), to rozwiązywałem testy IQ.
Teraz to reaguje "xD" na osoby przejmujące się nimi, krwa nie potrafimy zdefiniować, czym jest inteligencja w ogóle, a chcemy ją mniej-więcej oszacować 1 numerkiem. Fakt, jest silna pozytywna korelacja między IQ a inteligencją, ale to już kg w totalu dużo lepiej oddają siłę człowieka, niż test matematyczno-abstrakcyjno-językowy.
Ludzie z IQ poniżej 80 mają tendencję do nie rozumienia abstraktów typu "jak by się ktoś czuł gdybyś zabił jego bliskiego".
Wyobraźcie sobie, że to prawda.
https://www.datapandas.org/ranking/average-iq-by-country
Czyli jak jesteś niżej niż top 20%, to masz już problemy z ogarnianiem abstrakcji, a to co z tymi, co są niżej? Przecież oni powinni się zabijać o własne nogi żyjąc gorzej niż aborygeni.
No nie, po prostu oni nie są wyszkoleni w kontekstach i przypadkach, które te testy IQ mierzą. Zacytowanie zdanie ma sens w przypadku badania ludzi, którzy mimo obcowania X czasu w szkole czy gdzie indziej nadal nie przyswoili dobrze pewnych konceptów. Dlaczego nie przyswoili? Prawdopodobnie bo (mówiąc brutalnie) są lekko, albo mocniej, upośledzenie.
IQ w najlepszym razie to taki cień rzucany przez inteligencje, na bazie którego próbuje się opisywać "obiekt pierwotny".
Zaloguj się aby komentować
#holubek #himilsbach #inteligencja #spatif #andrzejgrabowski #anegdota #filmpolski

Zaloguj się aby komentować

Ludzie epoki kamienia odznaczali się większą inteligencją i wiedzą, niż chcemy przyznać
Na południu Hiszpanii, w miejscowości Antequera, znajduje się jedna z największych megalitycznych struktur w Europie, Dolmen de Menga. Ten olbrzymi tumulus (grobowiec) powstał niemal 6000 lat temu. Po raz pierwszy został zbadany w latach 40. XIX wieku i od tamtego czasu fascynuje archeologów....
18+
Treść dla dorosłych lub kontrowersyjna

Coś się dzieje z ludzką inteligencją?
Przez dziesiątki lat obserwowano interesujące zjawisko rozwoju intelektualnego naszego gatunku. Stanowiło to swego rodzaju wyzwanie dla osób badających poziom intelektualny kolejnych pokoleń, ponieważ trzeba było modyfikować narzędzia, żeby móc sprawnie badać nimi coraz mądrzejsze dzieci....

Sapioseksualizm – fakty i mity. Czym jest pociąg intelektualny?
Nazwa opisująca pociąg seksualny do inteligencji, bo taka jest najprostsza definicja sapioseksualizmu, zrobiła kilka lat temu zawrotną karierę. Deklaracja zainteresowania przede wszystkim umysłem potencjalnego partnera seksualnego bywa traktowana jako randkowy wabik. Zanim jednak ją złożymy, warto...
Było ujęcie, że inteligencja to jest zdolność rozwiązywania problemów.
Ale można też po prostu znać gotowe rozwiązania problemów, po prostu wyuczone, wtedy wystarczy podążać ścieżką według gotowego rozwiązania, wyciągniętą z pamięci.
Jest ujęcie, że inteligencja, to jest dobra kompresja danych, że sztuczna inteligencja to też na tym polega, tak powstaje model. A kompresja, to po prostu odnalezienie analogii, żeby móc coś upakować w mniejszym rozmiarze.
W mózgu też tak to działa.
Jakby to pociągnąć, to wyobraź sobie rozpakowane dane, z bardzo inteligentnego mózgu/modelu. To by była masa gotowych rozwiązań problemów, do każdej możliwej sytuacji.
Po tym rozwiązanie problemu, to już nie inteligentne myślenie, tylko przelecenie po (tych rozpakowanych) w pamięci gotowych rozwiązań, i zastosowanie ich.
Czyli ostatecznie wszystko sprowadziłoby się do zastosowania gotowych rozwiązań problemów, trzeba tylko zestawić problem z rozwiązaniem, i gotowe.
Inteligencja teoretycznie tworzy coś na poczekaniu, ale można spojrzeć na inteligencję w ten sposób, że to i tak jest lecenie sobie gotowymi rozwiązaniami, gotowymi ścieżkami.
#artificialintelligence #ai #inteligencja #mozg #iq #gpt
@fewtoast Inteligencja nie tworzy niczego ex nihilo. Wszystko, do czego może inteligencja dojść, to złożenie wzorców poznanych i wywnioskowanych.
Jedynie złożoność maszynerii odpowiedzialnej za składanie wzorców wedle reguł statystycznego prawdopodobieństwa, a także mnogość samych wzorców powodują, że powstaje złudzenie tworzenia.
Nie jest to jednak składanie wzorców całościowych w jedno, a ich odwzorowań, a właściwie poszczególnych części wektorów odwzorowań. Stąd, nie jest to tak łatwe, jak zwyczajne składanie gotowców. I wynik takiego składania może być nieintuicyjny Bo postrzeganie znacząco przetwarza informację wejściową, właśnie na owe wektory.
Do tego dochodzą wyspecjalizowane mechanizmy generujące, dodające syntetyczną informację, do tej odebranej ze zmysłów. I jeszcze mechanizmy wstępnego przetwarzania, takie jak usuwanie elementów niepasujących, zakłóceń.
Inteligencja nie jest z pewnością mechanizmem analitycznym, to znaczy takim, który bazuje na twardych przesłankach i racjonalnym wnioskowaniu z rzeczywistości. Głównie dlatego, że mechanizmy inteligencji to mechanizmy bazujące na wnioskowaniu statystycznym z niepełnych danych.
Racjonalne wnioskowanie jest wysoce niewydajne (choć czasem niezbędne), więc specjalizacja isnieje przede wszystkim na poziomie wnioskowania statystycznego.
Zaloguj się aby komentować

Restauracje fast food czynią nas nie tylko grubszymi, ale też głupszymi
Nowe badanie pokazuje, że restauracje fast food mają negatywny wpływ na społeczeństwo. O ile jego wpływ na BMI młodych osób nie jest niczym zaskakującym, o tyle okazuje się, że zmianie ulegają także zdolności poznawcze.
Najnowsze szacunki sugerują, że około 60% Norwegów w wieku 15-24 lat je...
Macie wewnętrzny dialog?
https://www.youtube.com/watch?v=7EIpwVHa_P8
#npc #inteligencja #dusza #swiadomosc #przemyslenia
Masz wewnętrzny dialog?
Zaloguj się aby komentować

AI, chmura i komputery kwantowe - jak działa polski IBM Lab
Laboratorium IBM w Krakowie stanowi ważny punkt na mapie rozwoju nowych technologii. To stąd w świat płyną patenty, a w tle rozwijane są pomysły, które zaczynają wchodzić w naszą codzienność. O misji IBM i jej znaczeniu na polskim rynku Interia rozmawia ze Sławomirem Kumką, szefem polskiego działu...





